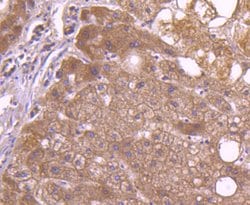
Invitrogen CD81 Recombinant Rabbit Monoclonal Antibody (SN206-01) 100 &mu;L;

Learn More
Invitrogen™ CD81 Recombinant Rabbit Monoclonal Antibody (SN206-01)


Rabbit Recombinant Monoclonal Antibody
Marke: Invitrogen™ MA532333
Beschreibung
Recombinant rabbit monoclonal antibodies are produced using in vitro expression systems. The expression systems are developed by cloning in the specific antibody DNA sequences from immunoreactive rabbits. Then, individual clones are screened to select the best candidates for production. The advantages of using recombinant rabbit monoclonal antibodies include: better specificity and sensitivity, lot-to-lot consistency, animal origin-free formulations, and broader immunoreactivity to diverse targets due to larger rabbit immune repertoire.
CD81 (TAPA-1, target of anti-proliferative antibody-1) is a member of the tetraspanin family, is expressed on virtually all nucleated cells, but above all on germinal center B cells. CD81 forms complexes with other tetraspanin proteins, integrins, coreceptors, MHC class I and II molecules, and influences adhesion, morphology, activation, proliferation and differentiation of B, T cells. In muscles, CD81 promotes cell fusion and myotube maintenance. CD81 has been also identified as a receptor for the hepatitis C virus. Like members of the tetraspanin family that include CD9, CD37, CD53, CD63, and CD82, CD81 is a cell-surface proteins that are characterized by the presence of four hydrophobic domains. The proteins mediate signal transduction events that play a role in the regulation of cell development, activation, growth and motility. CD81 is a cell surface glycoprotein that is known to complex with integrins. CD81 appears to promote muscle cell fusion and support myotube maintenance. CD81 associates with CD19, CD21, Leu 13, and integrins on cell membrane and acts as a receptor for the envelope protein E2 of chronic hepatitis C virus. Antibodies to CD81 have anti-proliferative effects on different lymphoid cell lines, particularly those derived from large cell lymphomas. CD81 is also localized in the tumor-suppressor gene region and is a candidate gene for malignancies.
Spezifikation
| CD81 | |
| Recombinant Monoclonal | |
| 1 mg/mL | |
| TBS with 0.05% BSA, 40% Glycerol and 0.05% sodium azide; pH 7.4 | |
| P35762, P60033, Q62745 | |
| CD81 | |
| Synthetic peptide within Human TAPA1/CD81 aa 161-210. | |
| 100 μL | |
| Primary | |
| Human, Mouse, Rat | |
| Antibody | |
| IgG |
| Flow Cytometry, Immunohistochemistry (Paraffin), Western Blot, Immunocytochemistry, Western Blot | |
| SN206-01 | |
| Unconjugated | |
| CD81 | |
| 26 kDa cell surface protein TAPA-1; CD 81 antigen; Cd81; CD81 antigen; CD81 antigen (target of antiproliferative antibody 1); CD81 molecule; CVID6; S5.7; Tapa1; Tapa-1; Target of the antiproliferative antibody 1; Tetraspanin28; tetraspanin-28; Tspan28; Tspan-28 | |
| Rabbit | |
| Protein A | |
| RUO | |
| 12520, 25621, 975 | |
| Store at 4°C short term. For long term storage, store at -20°C, avoiding freeze/thaw cycles. | |
| Liquid |
Bitte geben Sie uns Ihr Feedback zu den Produktinhalten, indem Sie das folgende Formular ausfüllen.